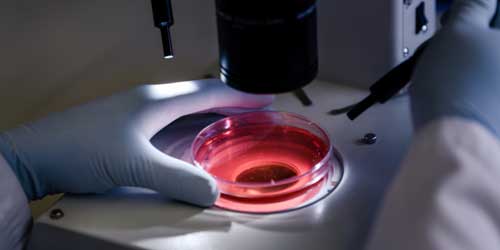

Cytology Testing at Assure Speciality Laboratory – Serving Kolkata, Sonamukhi & Purulia
At Assure Speciality Laboratory, we provide advanced cytology testing services across our fully-equipped branches in Kolkata, Sonamukhi, and Purulia, West Bengal. Cytology is a crucial diagnostic technique that examines cells to detect diseases such as cancer, infections, and inflammatory conditions. By analyzing cell samples from various body fluids or tissue scrapings, cytology enables early diagnosis and timely medical intervention, improving treatment outcomes significantly.
Our laboratories are staffed by skilled cytopathologists and supported by the latest diagnostic technology to ensure high precision and consistency in test results. Whether it’s a routine Pap smear or a targeted FNAC (Fine Needle Aspiration Cytology) for a suspicious lump, our team delivers reports that clinicians can trust.